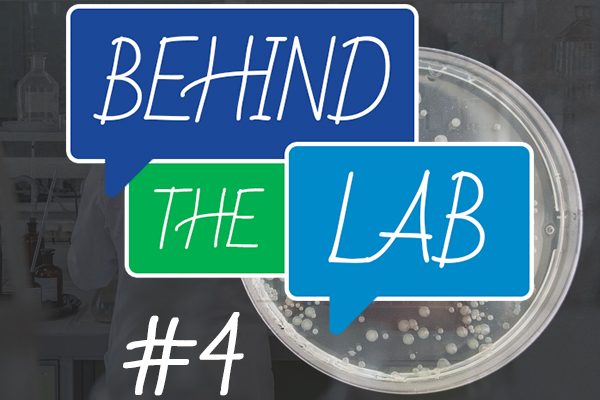
Behind The Lab 4

Le quatrième numéro de "Behind The Lab" est en ligne ! Pour rappel - et pour ceux qui ont manqué les trois premiers numéros (dépêchez-vous de vite les découvrir !) - "Behind The Lab" est une série d'interviews des membres de l'UMR 1092 RESINFIT. Behind The Lab est une référence à peine cachée à "Behind The Scenes" pour le cinéma. De quoi s'agit-il exactement ? Nous vous proposons de découvrir notre équipe (composée de chercheurs, professeurs, doctorants, post-doctorants, étudiants, etc.) au travers d’une série de questions. Leur travail, leurs missions, leurs motivations, la vie au sein du laboratoire et bien d’autres choses... nos collaborateurs vous disent (presque) tout ! Ce mois-ci, c'est Morgane Maniveau, doctorante au sein de l’unité (Axe : Eléments génétiques mobiles), qui s’est prêtée au jeu des questions/réponses afin de partager son expérience et son vécu. Sans oublier les "questions dilemme" pour apporter un peu de légèreté à cette interview. Un grand merci à elle pour sa participation !
Cliquez sur l'image pour découvrir le n°4 de Behind The Lab ⬇️
25 avril 2024
Behind The Lab #4 : l’interview des membres de l’unité !
Le quatrième numéro de « Behind The Lab » est en ligne ! Pour rappel – et pour ceux qui ont manqué les trois premiers numéros [...]
23 avril 2024
Antibiorésistance et projet EU-JAMRAI : une interview de Marie-Cécile Ploy pour Medscape
Ce n’est un secret pour personne, l’épidémiologie de la résistance aux antimicrobiens est complexe et doit être envisagée de [...]
9 avril 2024
L’Europe organisée dans la lutte contre l’antibiorésistance : un éditorial de Yohann Lacotte et Marie-Cécile Ploy dans la revue Hygiènes
Le projet EU-JAMRAI 2 est une action conjointe européenne sur la résistance aux antimicrobiens et les infections associées aux soins, qui [...]
8 avril 2024
Offre d’emploi – Assistant(e) Moodle / Administrateur(trice) de plateforme e-learning
L’Inserm est le seul organisme public français entièrement dédié à la recherche biologique, médicale et en santé des populations. Il dispose [...]
4 avril 2024
Comprendre le virus SARS-CoV-2 et ses modes d’action pour mieux agir et vivre avec : le projet CoviZion en vidéo avec Sophie Alain
Le projet de recherche interdisciplinaire CoviZion est un projet lauréat de l’appel à projets « AMI Flash Recherche & Innovations [...]
3 avril 2024
Offre de thèse : « Identification métagénomique des moteurs de la transmission de la résistance aux antimicrobiens à travers les écosystèmes One Health »
Dans le cadre de ses activités de recherche, l’UMR 1092 RESINFIT propose une offre de thèse : « Identification métagénomique des moteurs de [...]
26 mars 2024
Soutenance de thèse réussie pour Mélanie Pimenta, doctorante au sein de l’UMR 1092 RESINFIT
En ce mois de mars, une soutenance de thèse a eu lieu pour une membre de l’UMR 1092 RESINFIT. Mélanie Pimenta est (était) doctorante au sein [...]
21 mars 2024
Cytomégalovirus, la pandémie invisible : Sophie Alain participe à la publication d’une tribune dans Le Monde
Afin d’alimenter le débat d’idées, le journal Le Monde publie chaque jour des tribunes de signataires extérieurs à la rédaction. [...]
18 mars 2024
Nouvelle publication de l’unité : « Modeling the impact of urban and hospital eco-exposomes on antibiotic-resistance dynamics in wastewaters »
Un nouveau papier auquel plusieurs membres de l’UMR Inserm 1092 RESINFIT ont participé (Marie-Cécile Ploy, Christophe Dagot) est accessible [...]
8 mars 2024
Ma thèse en 180 secondes : un succès au concours de vulgarisation scientifique pour les doctorantes de l’unité
Le concours départemental de « Ma thèse en 180 secondes », ou MT180s, est organisé par le Collège des Écoles Doctorales de [...]